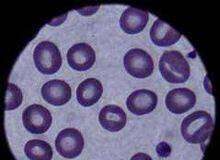
Uskontokunnat syntimittarista: Verestä ei syntejä näe

Seurakuntatyön johtajalle valta päättää nopeasta katastrofiavusta
Viime syksyn Taifuuni Filippiineillä herätti Tampereen seurakuntien yhteisessä kirkkoneuvostossa keskustelua siitä, miten seurakuntien katastrofiavun myöntämistä voitaisiin nopeuttaa.
Nyt yhteinen kirkkoneuvosto päätti kokouksessaan 23.1.2014, että yhteisen...
”Pappi tarvitsee samaa ravintoa jota jakaa”
Kuka olet ja milloin jäit eläkkeelle? Kuinka pitkän työrupeaman teit kirkon palveluksessa? Missä ja millaisessa tehtävässä?
...
Kirkon kulttuuripalkinto Ulla-Lena Lundbergille – Katso video
Kirkon kulttuuripalkinto 2013 myönnettiin kirjailija Ulla-Lena Lundbergille romaanistaan Jää (Is, Teos & Schildts & Söderströms). Arkkipiispa Kari Mäkinen jakoi palkinnon tiistaina 21.1. kirkkohallituksen juhlasalissa...
Mainonnan eettinen neuvosto selvittelee syntimittaria
Mainonnan eettinen neuvosto selvittelee, onko syntimittari.fi- ja dropper.fi-sivustolla mainostaminen hyvän tavan vastaista.
Asiasta on pyydetty lausuntoa, kertoo syntimittarista vastaavan Mikkoskopia-toiminimen omistava Mikko Vapa. Syntimittarin idea...
Uskontokunnat syntimittarista: Verestä ei syntejä näe
Mikkoskopia-toiminimen takana oleva Mikko Vapa kertoi Kotimaa24:lle eilen saaneensa tukea synnin mittaamiselle verestä helluntaiseurakunnan, Jehovan todistajien ja mormonikirkon yksittäisiltä edustajilta.
Hänen tuntemansa henkilöt olisivat siis...
”Kirkon voima ei ole sen johtajissa”
On sanottu monen suulla, että Suomessa vallitsee juuri nyt innoton ilmapiiri. Innostus on kateissa. Apea ja negatiivinen...
DBTL:ssä naimisiin reilussa sadassa metrissä
Turun ja Kaarinan seurakuntayhtymän ”Tahdon By The Laituri” aikoo nostattaa Down By The Laituri -rock-festivaaleilla Turussa hiukset pystyyn niin hääparilta kuin vihkipapilta.
Viime kesän...
Kaisa Raittila Tuomasyhteisön hallituksen puheenjohtajaksi
Helsingin Tuomasyhteisön uusi, syyskokouksessa valittu hallitus kokoontui eilen keskiviikkona ensimmäistä kertaa tänä vuonna ja valitsi puheenjohtajakseen Kaisa Raittilan.
Hallituksen puheenjohtaja vastaa yhdistyksen toiminnasta yhteistyössä toiminnanjohtaja...
Luostarin johtaja tulipalosta: ”Onni onnettomuudessa”
Valamon luostarin johtaja, arkkimandriitta Sergei näkee Valamon rakennuspalossa hyviäkin puolia. Varastorakennus ja sen vieressä ollut verstas tuhoutuivat keskiviikkoiltana sattuneessa tulipalossa Valamon luostarissa Heinävedellä.
– Eihän...
Keksintösäätiö kiistää rahoittaneensa syntimittaria
Keksintösäätiö kiistää, että se olisi tukenut Droppi Veripalveluun liitetty syntimittaria, jolla voitaisiin mitata ihmisten syntisyyttä verestä.
– Ei pidä paikkaansa. Olen tänä aamuna käynyt läpi...